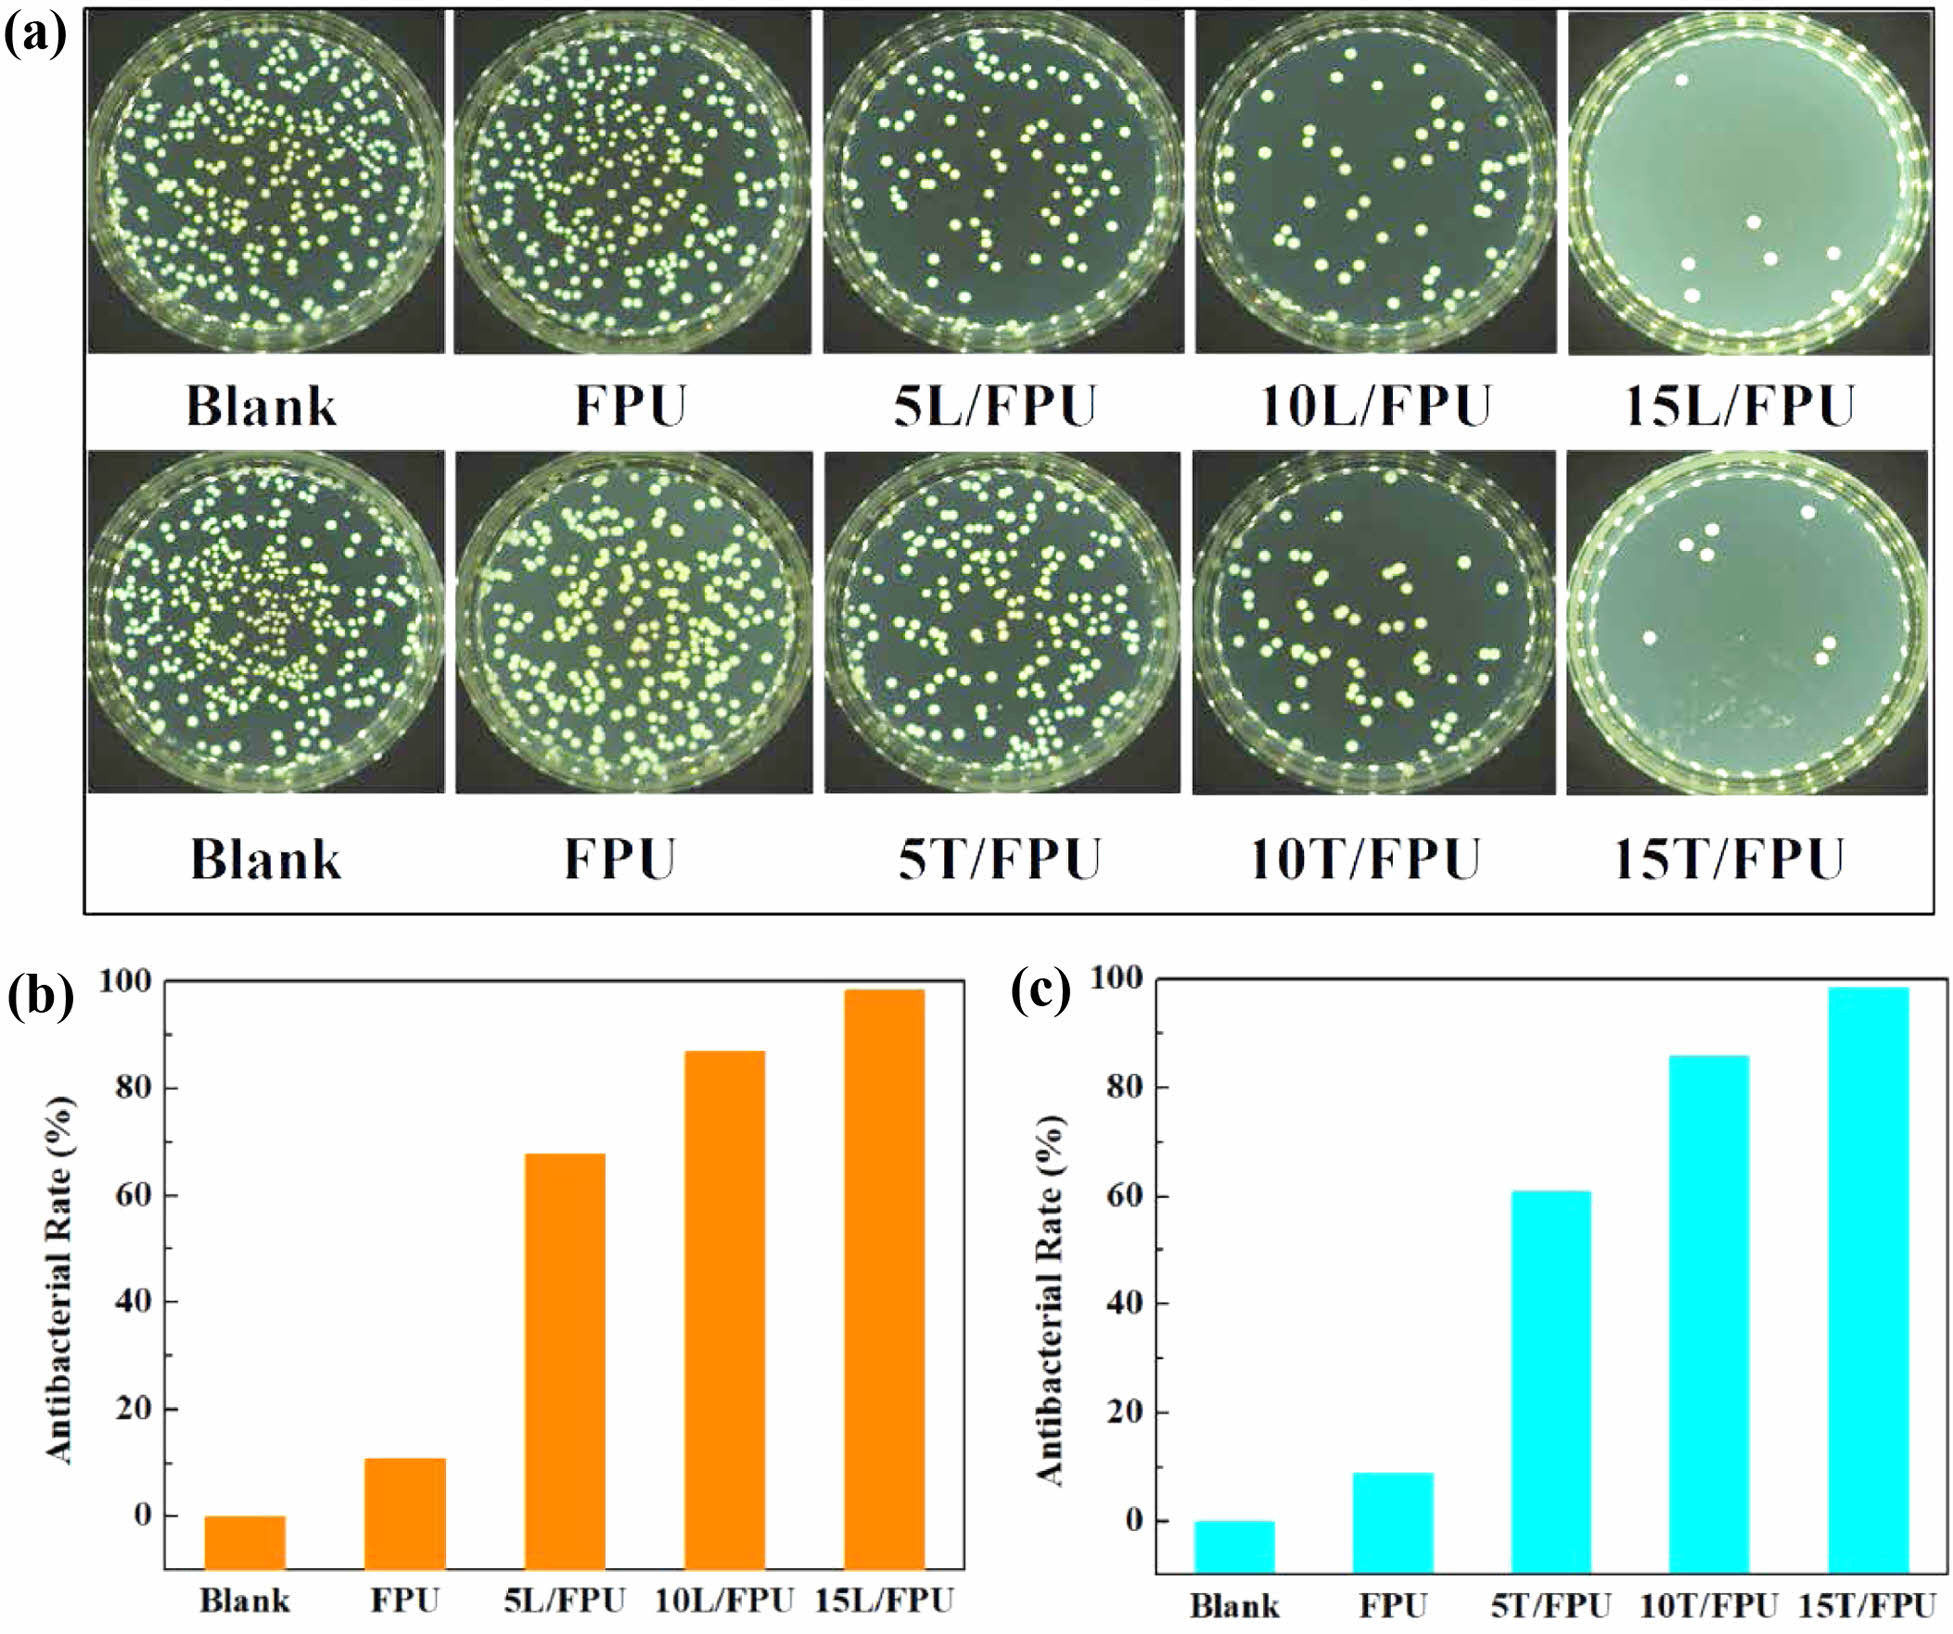

- Intrinsic Antibacterial Polyurethane Foam from Terpineol and Linalool: Synthesis and Properties
Qun Li*, **, Jinjiong Hong*, **, Yidong Wu*, **,†
 , and Ruixia Hou***
, and Ruixia Hou****Department of Otorhinolaryngology Head and Neck Surgery, the Affiliated Lihuili Hospital, Ningbo University, Ningbo, Zhejiang 315040, China.
**Department of Otorhinolaryngology Head and Neck Surgery, Ningbo Medical Centre Lihuili Hospital, Ningbo, Zhejiang 315040, China.
***Department of Cell Biology and Regenerative Medicine, Health Science Center, Ningbo University, Ningbo, Zhejiang 315211, China- 테르피네올과 리날룰로부터 얻은 고유 항균 폴리우레탄 폼: 합성 및 성질
Reproduction, stored in a retrieval system, or transmitted in any form of any part of this publication is permitted only by written permission from the Polymer Society of Korea.
The development of foam polyurethane (FPUs) materials endowed with antibacterial capabilities holds immense significance in numerous fields. Therefore, the endeavor to enhance their antibacterial functionality assumes a position of utmost importance. In this work, two series of antibacterial modified foam polyurethanes with inherent antibacterial properties were obtained by introducing linalool and terpineol into commercial FPU systems. FPU systems were prepared by mixing poly(diphenylmethane diisocyanate), polyether polyol, foaming agent, and different amounts of linalool or terpineol. The influence of different modified monomer (linalool and terpineol) contents on the mechanical, thermal, and antibacterial properties of FPU systems were systematically investigated. Characterization techniques such as Fourier transform infrared (FTIR), thermogravimetric analysis (TGA), mechanical testing, and scanning electron microscope (SEM) were employed in here. These results indicated that the compressive strength of linalool-modified FPU systems decreased with increased linalool content due to its soft fatty chains. In contrast, terpineol-modified FPU systems exhibited increased compressive strength because of its rigid fatty ring. The thermal stability of FPU systems was enhanced with the addition of linalool and terpineol, attributed to the conjugated double bonds in their structures. SEM analysis revealed similar cell structures in FPU systems with different modified monomer contents, suggesting that changes in compression properties were primarily due to the introduced flexible or rigid structures of the modified monomer. Antibacterial tests following ISO 22196:2007 guidelines, using Escherichia coli as the model strain, demonstrated that the bactericidal rate of the linalool-modified FPU systems increased from 10.7% to 98.4%, and that of terpineol-modified FPU systems rose from 8.8% to 98.4% with higher monomer content. These findings indicate that modified FPU systems retain the antibacterial properties of linalool and terpineol, providing valuable insights for developing high performance antibacterial foam polyurethane.
This study synthesizes intrinsic antibacterial foam polyurethanes (FPUs) by incorporating natural plant extracts linalool and terpineol into commercial FPU systems, systematically investigating the effects of monomer content on mechanical, thermal, and antibacterial properties. The modified FPUs show enhanced thermal stability and antibacterial activity (up to 98.4% bactericidal rate against Escherichia coli), with linalool reducing compressive strength due to its soft chains and terpineol increasing it via its rigid ring structure. These findings provide valuable insights for developing high-performance antibacterial FPU materials for diverse practical applications.

Keywords: foam polyurethane, antibacterial, linalool, terpineol.
The authors are grateful for the financial support from Zhejiang Provincial Medical and Health Science Research Foundation (2022KY295), Ningbo Top Medical and Health Research Program (No. 2023030514), Ningbo “Technology Innovation 2025” Major Special Project (2020Z097), Ningbo Natural Science Foundation (2023J030)
The authors declare that they have no known competing financial interests or personal relationships that could have appeared to influence the work reported in this paper.
Thermosetting polyurethane (PU), a thermosetting polymer distinguished by its abundant urethane groups along its backbone, is synthesized through the foaming polymerization of isocyanate and polyol, facilitated by specific additives.1-3 Based on variations in hardness, foam polyurethane materials can be categorized into three distinct types: rigid foam PU, flexible foam PU, and semi-rigid foam PU. Due to their unique characteristics, these diverse polyurethane formulations have widely applied in household appliances, construction materials, transportation systems, automotive components, and numerous other industries.4-6 Nonetheless, polyurethane materials inherently lack antibacterial properties, making them susceptible to bacterial colonization. This susceptibility not only accelerates material degradation but also escalates the potential for human infection. Consequently, the incorporation of antibacterial functionality into foam polyurethane materials assumes paramount importance.7-9
Given the wide-spread applications of foam polyurethane in diverse sectors such as healthcare, where it is used in items like hospital mattresses and medical packaging, and in the food industry, for food-contact foams and insulating materials, the absence of antibacterial features leaves these products vulnerable to bacterial invasion.10-12 The primary strategy for fabricating antibacterial foam polyurethane materials predominantly revolves around incorporating antibacterial agents. This strategy can be essentially categorized into two distinct approaches.13 One approach entails directly integrating antibacterial agents into FPU materials via blending or immersion. However, the extensive use of this method has led to a remarkable escalation of bacterial resistance and environmental pollution issues. Given this scenario, researchers vigorously seek non-toxic natural antibacterial agents as viable alternatives, such as ZnO,14 silver metal nanoparticles,15 chitosan,16 polyphenols,17 olefinic compounds,18 etc. Among these, silver and Tion2 demonstrate broad-spectrum bactericidal capabilities. However, precisely controlling their release processes remains a challenge. Organic antibacterial agents typically function by interacting with cell membranes. Nevertheless, chitosan confronts issues like restricted water solubility, antibacterial peptides are plagued by instability, and small-molecule quaternary ammonium salts may exhibit cytotoxicity and be hampered by resistance problems. Another approach involves integrating antibacterial substances into the polyurethane system through chemical reactions. These antibacterial substances are typically cationic polymers with terminal hydroxyl groups.19 They can be covalently attached to the polyurethane molecular chains by reacting with -NCO groups, forming urethane linkages. Cationic polymers, acting as positively charged bactericidal agents, exert their antibacterial effects by interacting with the negatively charged bacterial cell membranes, leading to membrane disruption and subsequent bacterial death. This method offers several advantages, such as prolonged efficacy, non-toxicity to humans, negligible impact on the properties of the polymer, and reduced likelihood of drug resistance development.20-22
Linalool, an extract derived from natural plants, demonstrates diverse biological activities, encompassing anticancer, antibacterial, antiviral, neuroprotective, anxiolytic, antidepressant, and antistress properties. Notably, linalool has substantial potential for application in the antibacterial and antifungal domains.23-25 Aytac et al. fabricated cyclodextrin/linalool inclusion complex nanofibers via electrospinning technology. The outcomes of the antibacterial experiments are remarkable. They reveal that the linalool released from these nanofibers can effectively suppress the growth of Escherichia coli and Staphylococcus aureus.26 Xie et al. developed a pH-responsive carboxymethyl chitosan (CMCS) hydrogel loaded with linalool Pickering emulsion for controlled drug release. This system enables triggered release in the acidic tumor microenvironment, demonstrating both biocompatibility and antitumor activity, offering a novel strategy for monoterpene delivery.27 Terpineol, another plant extract of natural origin, has exhibited remarkable effectiveness in eradicating various bacteria and fungi that are primary causative agents of human diseases.28-30 Tang et al. engineered an AceLNT-g-a-ter membrane by conjugating acetylated lentinan with α-terpineol. This hybrid system achieved 80-85% reduction in bacterial adhesion and 70-71% decrease in biofilm formation for Escherichia coli and Pseudomonas aeruginosa after 7 day incubation.31 Costa Pereira et al. developed self-disinfecting paints containing Chloroxylenol (CLX), a-Terpineol (TRP), and their combination. This system demonstrated significant antibacterial activity (>80% reduction) against Gram-positive and Gram-negative bacteria before and after scrub resistance testing, while maintaining cellular viability (>70%) and minimal genotoxicity in human cell lines.32 These research findings undoubtedly offer novel insights into the development of antibacterial materials.
This research explores the potential of applying two natural plant extracts, terpineol and linalool. These two monomers are innovatively applied to modify the foam polyurethane systems, aiming to endow the foam materials with excellent antibacterial properties. During the research process, the impact of the varying contents of terpineol and linalool monomers on several crucial performance indices of the foam polyurethane systems was systematically studied. Specifically, the effects of different monomer contents on the foam polyurethane systems's mechanical properties, thermal properties, and antibacterial properties were recorded in detail. This in-depth study not only contributes to a deeper understanding of the interaction mechanism between natural plant extracts and polyurethane foams but also lays a foundation for developing high performance antibacterial foam polyurethane materials.
Materials and Methods. Materials. Poly(diphenylmethane diisocyanate) (PM-200) was purchased from Wanhua Chemical Group Co., Ltd. Polyether polyol (330N) was purchased from Shandong Blue Star Dongda Co., Ltd. Foaming agent (FA) was purchased from Huntsman International Co., Ltd. Terpineol (98%) dibutyl tin dilaurate (DBTL) and linalool (98%) were purchased from Shanghai Aladdin Biochemical Technology Co., Ltd. All raw materials were used directly without purification.
Preparation of Foam Polyurethane (FPU). The FPUs corresponding to Scheme 1 were prepared through a controlled fabrication process using a precursor mixture with optimized components. The manufacturing procedure commenced with precise blending of predetermined quantities of 330N, FA, terpineol, and linalool (formulation ratios detailed in Table 1) through mechanical homogenization. PM-200 was then incorporated into the homogeneous mixture under continuous mechanical agitation at 1000 rpm for 30 seconds to ensure uniform dispersion. The activated mixture was subsequently transferred into pre-treated silicone molds and allowed to undergo complete cross-linking. Following demolding, the cured FPUs were maintained in a climate-controlled environment (25 ℃, 30% RH) for 48 h to achieve structural stabilization prior to subsequent characterization and application testing.
Scheme 1. The corresponding photos of the FPU.
Characterization. Fourier transform infrared (FTIR) was employed to analyze the chemical compositions of the obtained FPU systems. FTIR spectra were acquired utilizing a Thermo Fisher Scientific Nicolet iS5 FTIR spectrometer operating in ATR (attenuated total reflectance) mode, and the spectral data are presented in units of cm−1. The thermogravimetric analysis (TGA) was performed using a TG/DTA 7300 instrument (Seiko, Chiba, Japan) under controlled atmospheric conditions. The experiments employed high-purity nitrogen as the carrier gas, maintained at a precisely controlled flow rate of 50 mL/min through mass flow regulators. Thermal profiling was executed across a programmed temperature spectrum from 50 ℃ to 800 ℃, implementing a linear heating gradient of 20 ℃/min under continuous mass loss monitoring. All measurements were conducted in triplicate to verify thermal decomposition reproducibility. The mechanical characterization was conducted on a universal mechanical testing machine (Model C43.104; MTS Systems, China) operating at a constant crosshead displacement rate of 2 mm/min. Prior to mechanical evaluation, all specimens underwent standardized conditioning at 25 ℃ ± 1 ℃ and 50% ± 5% relative humidity for 24 h to achieve environmental equilibrium. Compression parameters were derived from the average of five consecutive measurements per sample, ensuring statistical reliability of the experimental data. The antibacterial performance of FPU systems was evaluated through a standardized experimental procedure following ISO 22196:2007 guidelines, employing Escherichia coli (ATCC 25922) as the model bacterial strain. The assessment was conducted using a dynamic vibration methodology to quantitatively determine the antimicrobial efficacy of the materials.
Characterization of Different FPU Systems. Figure 1 presents the FTIR spectra of different FPU systems, namely the linalool modified FPUs and the terpineol-modified FPUs, respectively. The specific preparation schematic is shown in Scheme 2.
Scheme 2. Specific preparation schematic of the FPU.
As clearly shown in Figure 1(a), the characteristic peak observed at 1225 cm-1, which corresponds to the C-N stretching vibrations in urethane linkages, demonstrates the covalent bonding formed between the isocyanate and polyol components during the synthesis of FPUs.33 The characteristic peaks at 1371 cm-1 and 1451 cm-1, associated with the aliphatic chain segments, reveal information about the chain structure. Additionally, the peak characteristic at 1670 cm-1 represents the stretching vibration absorption peak linked to the -C=CH2 double bond in the linalool-modified FPUs, indicating successful linalool incorporation.34 Meanwhile, similar peak assignments can be seen in the FTIR spectrum of the linalool modified FPUs. In summary, these results clearly show that both linalool and terpineol have been successfully introduced into the FPU systems. This achievement unlocks new ways to adjust the properties of FPU systems for different applications.
Thermal and Mechanical Properties of Different FPUs. Figure 2 displays the thermogravimetric curves of various FPU systems under an inert nitrogen atmosphere, with Table 1 providing the key degradation parameters: the 5% decomposition temperature (Td5%) and the residual carbon content measured at 800 ℃ (R800). Remarkably, all FPU systems exhibited stability at temperatures below 260 ℃. The Td5% values, ranging from 278 ℃ to 292 ℃, indicate outstanding initial thermal stability. As depicted in Figure 2(a), the Td5% of the linalool modified FPU systems increased from 278 ℃ to 292 ℃ with an increase in linalool content. This can primarily be attributed to the conjugated double bonds within the linalool structure, which enhance the thermal stability of the system. Similarly, as shown in Figure 2(b), the Td5% of the terpineol modified FPU systems rose from 278 ℃ to 288 ℃ with increasing terpineol content. This phenomenon is driven by the same mechanism, involving the stabilizing effect of the conjugated double bonds in terpineol. Furthermore, the R800 of the linalool-modified FPU and the terpineol modified FPU systems showed a progressive increase from 5.9% to 15.7% with the incremental addition of linalool and terpineol, respectively. This enhancement in char formation can be mechanistically linked to the increased double bond content within these additives, which promotes crosslinking reactions during pyrolysis.35,36
Compression experiments were conducted to assess the impact of natural alcohols (linalool and terpineol) on the mechanical properties of FPU systems. The results obtained from these experiments are graphically represented in Figure 3. As shown in Table 2, the Pure FPU has an average tensile strength of 202 KPa. The compressive strength of the linalool-modified FPUs demonstrates a decreasing trend with the addition of linalool. When the linalool content attains 15 wt% of component B, the compressive strength of the modified FPUs decreases to 134 KPa. This reduction can be ascribed to the soft fatty chains within the linalool molecular structure. In contrast, the compressive strength of the terpineol-modified FPUs shows an upward tendency with the incremental addition of terpineol. Specifically, when the proportion of terpineol reaches 15 wt% in component B, the compressive strength increases to 332 KPa. This can be mainly attributed to the rigid fatty ring in the terpineol structure.
In order to verify whether the significant changes in the compression properties of foam are mainly due to the structural specificity of the different modified monomers (linalool and terpineol) or the changes in the internal cell structure of the FPU systems, the different FPU specimens were analyzed by scanning electron microscope (SEM). The result is shown in Figure 4. These results indicate that the FPU systems with different modified monomers (linalool and terpineol) contents possess similar cell structures. Therefore, the changes in the compression properties of the different FPU specimens are mainly due to the alterations resulting from the introduction of flexible or rigid structures.
Antibacterial Properties of the Linalool-modified FPUs and the Terpineol-modified FPUs. In compliance with ISO 22196:2007 standards, Escherichia coli (ATCC 25922) was selected as the test organism for antibacterial evaluation. The antimicrobial performance of different FPU specimens was quantitatively determined through the dynamic contact method. Prior to analysis, all FPU specimens underwent sequential solvent cleaning (ethanol/deionized water, 3 cycles) followed by vacuum-drying at 100 ℃ for 24 h to eliminate organic residues and achieve constant mass (±0.2% weight variation tolerance).
Figure 5 illustrates the photographs and elimination rate of Escherichia coli following 24 hours of contact with the different FPU specimens. As presented in Figure 5(b), with the incremental addition of linalool, the bactericidal rate of the linalool modified FPUs against Escherichia coli escalated from 10.7% to 98.4%. Simultaneously, as depicted in Figure 5(c), as the amount of terpineol added increased, the bactericidal rate of the terpineol-modified FPUs against Escherichia coli rose from 8.8% to 98.4%. These outcomes suggest that the modified FPUs maintain the intrinsic antibacterial characteristics of linalool and terpineol.

|
Figure 1 FTIR of (a) the linalool-modified FPUs; (b) the terpineol-modified FPUs. |

|
Figure 2 TGA curves for (a) the linalool-modified FPUs; (b) the terpineol-modified FPUs. |

|
Figure 3 Compression curves for (a) the linalool-modified FPUs; (b) the terpineol-modified FPUs. |

|
Figure 4 SEM images for the linalool-modified FPUs and the terpineol-modified FPUs. |
|
Figure 5 Photographs of Escherichia coli for different FPU specimens: (a) antibacterial rate of Escherichia coli for different the linaloolmodified; (b) terpineol-modified; (c) FPU specimens. |
|
Table 2 TGA Properties for the Linalool-Modified FPUs and the Terpineol-Modified FPUs |

In this work, two series of antibacterial modified FPUs with inherent antibacterial properties were successfully obtained by introducing linalool and terpineol into commercial FPU systems. After the introduction of the natural antibacterial alcohols (linalool and terpineol), the thermal stability and antibacterial performance of the modified FPU systems were both significantly improved. The Td5% values of linalool-modified FPU systems increased from 278 ℃ to 292 ℃, whereas terpineol modified FPU systems rose from 278 ℃ to 288 ℃. Meanwhile, the bactericidal rate of linalool-modified FPU systems increased from 10.7% to 98.4%, while terpineol-modified FPU systems demonstrated a similar tetrend, the bactericidal rate rose from 8.8% to 98.4%.
In summary, the integration of linalool or terpineol into FPUs imparts significant antibacterial efficacy, enabling the design of advanced antibacterial FPUs for practical applications. Certainly, this study has limitations, particularly regarding the long-term service stability of FPUs. In future research, we will focus on investigating the long-term antibacterial properties of FPUs.
- 1. Kim, S.; Li, K.; Alsbaiee, A.; Brutman, J. P.; Dichtel, W. R. Circular Reprocessing of Thermoset Polyurethane Foams. Adv. Mater. 2023, 35, 2305387.
-

- 2. Yang, F.; Cong, L.; Li, Z.; Yuan, J.; Guo, G.; Tan, L. Study on Preparation and Performance of a Thermosetting Polyurethane Modified Asphalt Binder for Bridge Deck Pavements. Constr. Building Mater. 2022, 326, 126784.
-

- 3. Liu, Z.; Fang, Z.; Zheng, N.; Yang, K.; Sun, Z.; Li, S.; Xie, T. Chemical Upcycling of Commodity Thermoset Polyurethane Foams Towards High-performance 3D Photo-printing Resins. Nat. Chem. 2023, 15, 1773-1779.
-

- 4. Silva, R.; Barros-Timmons, A.; Quinteiro, P. Life Cycle Assessment of Fossil-and Bio-based Polyurethane Foams: A Review. J. Cleaner Production, 2023, 430, 139697.
-

- 5. Skleničková, K.; Abbrent, S.; Halecký, M.; Kočí, V.; Beneš, H. Biodegradability and Ecotoxicity of Polyurethane Foams: A Review. Critical Reviews in Environ. Sci. Technol. 2022, 52, 157-202.
-

- 6. Rastegar, N.; Ershad-Langroudi, A.; Parsimehr, H.; Moradi, G. Sound-absorbing Porous Materials: A Review on Polyurethane-based Foams. Iranian Polym. J. 2022, 31, 83-105.
-

- 7. Lin, B.; Yuen, A. C. Y.; Oliver, S.; Liu, J.; Yu, B.; Yang, W.; Wang, C. H. Dual Functionalisation of Polyurethane Foam for Unprecedented Flame Retardancy and Antibacterial Properties Using Layer-by-layer Assembly of MXene Chitosan with Antibacterial Metal Particles. Compos. Part B: Eng. 2022, 244, 110147.
-

- 8. Moawed, E. A.; Eissa, M. S.; Al-Tantawy, S. A. Application of Polyurethane Foam/zinc Oxide Nanocomposite for Antibacterial Activity, Detection, and Removal of Basic Dyes from Wastewater. Int. J. Environ. Sci. Technol. 2023, 20, 7767-7774.
-

- 9. Zhang, S.; Shi, X.; Miao, Z.; Zhang, H.; Zhao, X.; Wang, K.; Zhang, G. 3D‐printed Polyurethane Tissue‐engineering Scaffold with Hierarchical Microcellular Foam Structure and Antibacterial Properties. Adv. Eng. Mater. 2022, 24, 2101134.
-

- 10. Sarkar, S.; Mestry, S.; Mhaske, S. T. Developments in Phase Change Material (PCM) Doped Energy Efficient Polyurethane (PU) Foam for Perishable Food Cold-storage Applications: A Review. J. Energy Storage 2022, 50, 104620.
-

- 11. Yu, M.; Park, K. H.; Shin, J.; Lee, J. H. Predicting the Cut‐off Point for Interface Pressure in Pressure Injury According to the Standard Hospital Mattress and Polyurethane Foam Mattress as Support Surfaces. Int. Wound J. 2022, 19, 1509-1517.
-

- 12. Sikdar, P.; Dip, T. M.; Dhar, A. K.; Bhattacharjee, M.; Hoque, M. S.; Ali, S. B. Polyurethane (PU) Based Multifunctional Materials: Emerging Paradigm for Functional Textiles, Smart, and Biomedical Applications. J. Appl. Polym. Sci. 2022, 139, e52832.
-

- 13. Vinay, V. C.; Varma, D. M.; Chandan, M. R.; Sivabalan, P.; Jaiswal, A. K.; Swetha, S.; Sionkowska, A. Study of Silver Nanoparticle-loaded Auxetic Polyurethane Foams for Medical Cushioning Applications. Polym. Bulletin 2022, 79, 4233-4250.
-

- 14. Moawed, E. A.; Eissa, M. S.; Al-Tantawy, S. A. Application of Polyurethane Foam/zinc Oxide Nanocomposite for Antibacterial Activity, Detection, and Removal of Basic Dyes from Wastewater. Int. J. Environ. Sci. Technol. 2023, 20, 7767-7774.
-

- 15. Huang, M.; Du, X. Synergistic Effect of Ag Nanoparticle and Graphene on Improving Antimicrobial and Photothermal Conversion Performances of Their Polyurethane Foam Sensor. Chem. Eng. J. 2025, 507, 160836.
-

- 16. Lin, B.; Yuen, A. C. Y.; Oliver, S.; Liu, J.; Yu, B.; Yang, W.; Wang, C. H. Dual Functionalisation of Polyurethane Foam for Unprecedented Flame Retardancy and Antibacterial Properties Using Layer-by-layer Assembly of MXene Chitosan with Antibacterial Metal Particles. Compos. Part B: Eng. 2022, 244, 110147.
-

- 17. Tomaselli, S.; Bertini, F.; Cifarelli, A.; Vignali, A.; Ragona, L.; Losio, S. Antibacterial Properties of Polyurethane Foams Additivated with Terpenes From a Bio-based Polyol. Molecules 2023, 28, 1966.
-

- 18. del Pilar Maya, M.; Torres, S.; Gartner, C. Synthesis and Surface Modification of Sunflower Oil‐based Non‐isocyanate Polyurethane: Physicochemical and Antibacterial Properties. J. Appl. Polym. Sci. 2024, 141, e55181.
-

- 19. Ecevit, K.; Silva, E.; Rodrigues, L. C.; Aroso, I.; Barros, A. A.; Silva, J. M.; Reis, R. L. Surface Functionalization of Ureteral Stents-based Polyurethane: Engineering Antibacterial Coatings. Materials 2022, 15, 1676.
-

- 20. Lv, X.; Li, Z.; Zhang, Z.; Wang, H.; Song, H.; Yuan, S.; Li, Z. Quaternary Ammonium Salt-Based Intrinsic Antibacterial Polyurethanes: Optimizing the Antibacterial Activity via Cationic Main-or Side-Chain Design in Hard Segments. ACS Appl. Mater. Interfaces, 2024, 16, 56862-56873.
-

- 21. Sienkiewicz, N. Improvements of Polyurethane (PU) Foam’s Antibacterial Properties and Bio-resistance. In Thermal Insulation and Radiation Control Technologies for Buildings. Cham. Springer International Publishing. 2022, 217-240.
-

- 22. Cui, M.; Li, S.; Ma, X.; Wang, J.; Wang, X.; Stott, N. E.; Zhu, J. Sustainable Janus Lignin-based Polyurethane Biofoams with Robust Antibacterial Activity and Long-term Biofilm Resistance. Int. J. Biological Macromol. 2024, 256, 128088.
-

- 23. Guo, F.; Chen, Q.; Liang, Q.; Zhang, M.; Chen, W.; Chen, H.; Chen, W. Antimicrobial Activity and Proposed Action Mechanism of Linalool Against Pseudomonas Fluorescens. Frontiers in Microbiol. 2021, 12, 562094.
-

- 24. Zhang, L.; Su, Q. F.; Wang, L. S.; Lv, M. W.; Hou, Y. X.; Li, S. S. Linalool: A Ubiquitous Floral Volatile Mediating the Communication Between Plants and Insects. J. Systematics Evolution, 2023, 61, 538-549.
-

- 25. Weston-Green, K.; Clunas, H.; Jimenez Naranjo, C. A Review of the Potential Use of Pinene and Linalool as Terpene-based Medicines for Brain Health: Discovering Novel Therapeutics in the Flavours and Fragrances of Cannabis. Front. Psychiatry, 2021, 12, 583211.
-

- 26. Aytac, Z.; Yildiz, Z. I.; Kayaci-Senirmak, F.; Tekinay, T.; Uyar, T. Electrospinning of Cyclodextrin/linalool-inclusion Complex Nanofibers: Fast-dissolving Nanofibrous Web with Prolonged Release and Antibacterial Activity. Food Chem. 2017, 231, 192-201.
-

- 27. An, Y.; Zhai, R.; Chen, J.; Xie, P. Preparation and Application of a Novel pH-responsive Linalool Carboxymethyl Chitosan Hydrogel. J. Macromol. Sci. Part A, 2023, 60, 336-345.
-

- 28. Sales, A.; Felipe, L. D. O.; Bicas, J. L. Production, Properties, and Applications of a-terpineol. Food Bioprocess Technol. 2020, 13, 1261-1279.
- 29. Park, S. N.; Lim, Y. K.; Freire, M. O.; Cho, E.; Jin, D.; Kook, J. K. Antimicrobial Effect of Linalool and a-terpineol Against Periodontopathic and Cariogenic Bacteria. Anaerobe, 2012, 18, 369-372.
-

- 30. Li, L.; Shi, C.; Yin, Z.; Jia, R.; Peng, L.; Kang, S.; Li, Z. Antibacterial Activity of a-terpineol May Induce Morphostructural Alterations in Escherichia coli. Brazilian J. Microbiol. 2014, 45, 1409-1413.
-

- 31. Ding, Q.; Zhuang, T.; Fu, P.; Zhou, Q.; Luo, L.; Dong, Z.; Tang, S. a-terpineol Grafted Acetylated Lentinan as An Anti-bacterial Adhesion Agent. Carbohydr. Polym. 2022, 277, 118825.
-

- 32. Querido, M. M.; Paulo, I.; Hariharakrishnan, S.; Rocha, D.; Barbosa, N.; Gonçalves, D.; Pereira, C. C. Development and In Vitro Validation of Antibacterial Paints Containing Chloroxylenol and Terpineol. Toxics, 2022, 10, 343.
-

- 33. Liu, L.; Lu, J.; Zhang, Y.; Liang, H.; Liang, D.; Jiang, J.; Zhang, C. Thermosetting Polyurethanes Prepared with the Aid of a Fully Bio-based Emulsifier with High Bio-content, High Solid Content, and Superior Mechanical Properties. Green Chem. 2019, 21, 526-537.
-

- 34. Zhuang, Y.; Ren, Z.; Jiang, L.; Zhang, J.; Wang, H.; Zhang, G. Raman and FTIR Spectroscopic Studies on Two Hydroxylated Tung Oils (HTO) Bearing Conjugated Double Bonds. Spectrochim. Acta Part A, 2018, 199, 146-152.
-

- 35. Dey, J.; Xu, H.; Shen, J.; Thevenot, P.; Gondi, S. R.; Nguyen, K. T.; Yang, J. Development of Biodegradable Crosslinked Urethane-doped Polyester Elastomers. Biomaterials, 2008, 29, 4637-4649.
-

- 36. Li, F.; Hanson, M. V.; Larock, R. C. Soybean Oil-divinylbenzene Thermosetting Polymers: Synthesis, Structure, Properties and Their Relationships. Polymer, 2001, 42, 1567-1579.
-

- Polymer(Korea) 폴리머
- Frequency : Bimonthly(odd)
ISSN 2234-8077(Online)
Abbr. Polym. Korea - 2024 Impact Factor : 0.6
- Indexed in SCIE
 This Article
This Article
-
2025; 49(6): 749-756
Published online Nov 25, 2025
- 10.7317/pk.2025.49.6.749
- Received on Apr 21, 2025
- Revised on Jul 16, 2025
- Accepted on Jul 16, 2025
 Services
Services
- Full Text PDF
- Abstract
- ToC
- Acknowledgements
- Conflict of Interest
Introduction
Experimental
Results and Discussion
Conclusions
- References
Shared
 Correspondence to
Correspondence to
- Yidong Wu
-
*Department of Otorhinolaryngology Head and Neck Surgery, the Affiliated Lihuili Hospital, Ningbo University, Ningbo, Zhejiang 315040, China.
**Department of Otorhinolaryngology Head and Neck Surgery, Ningbo Medical Centre Lihuili Hospital, Ningbo, Zhejiang 315040, China. - E-mail: wyd330282@163.com
- ORCID:
0009-0005-8438-7621









 Copyright(c) The Polymer Society of Korea. All right reserved.
Copyright(c) The Polymer Society of Korea. All right reserved.